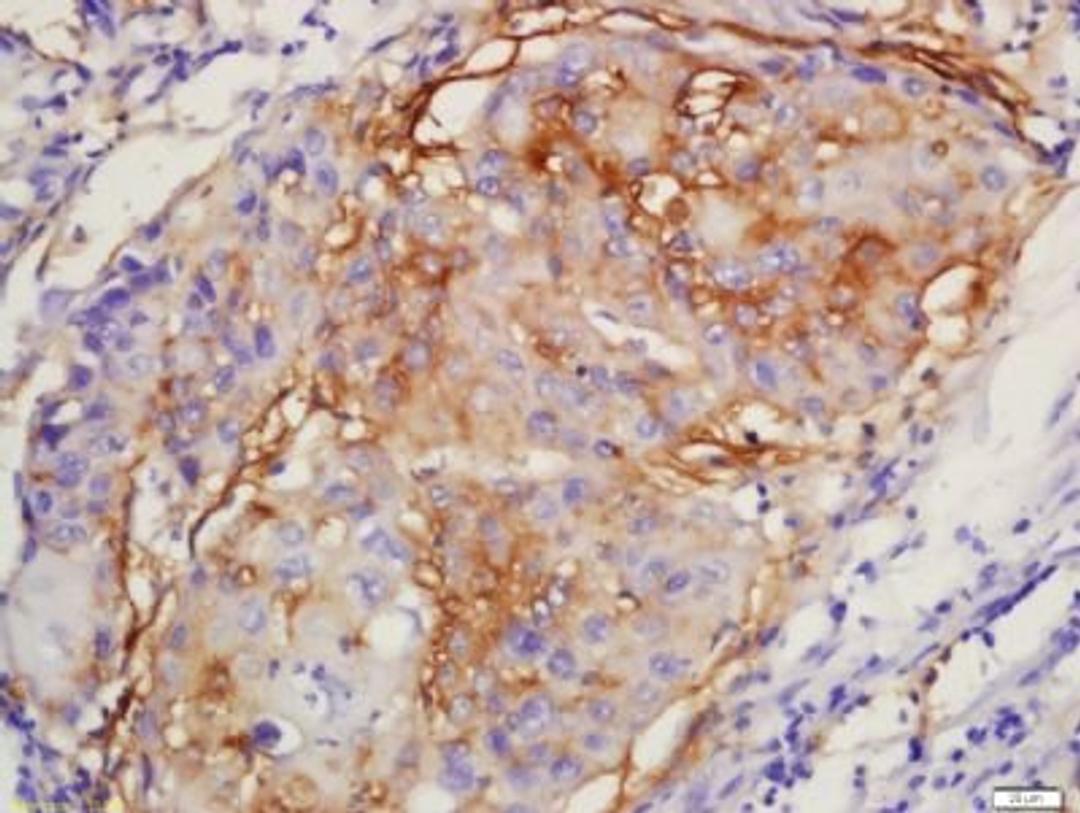
Immunohistochemical staining of human lung cancer tissue using ERK1 (phospho-Thr183-185) antibody.
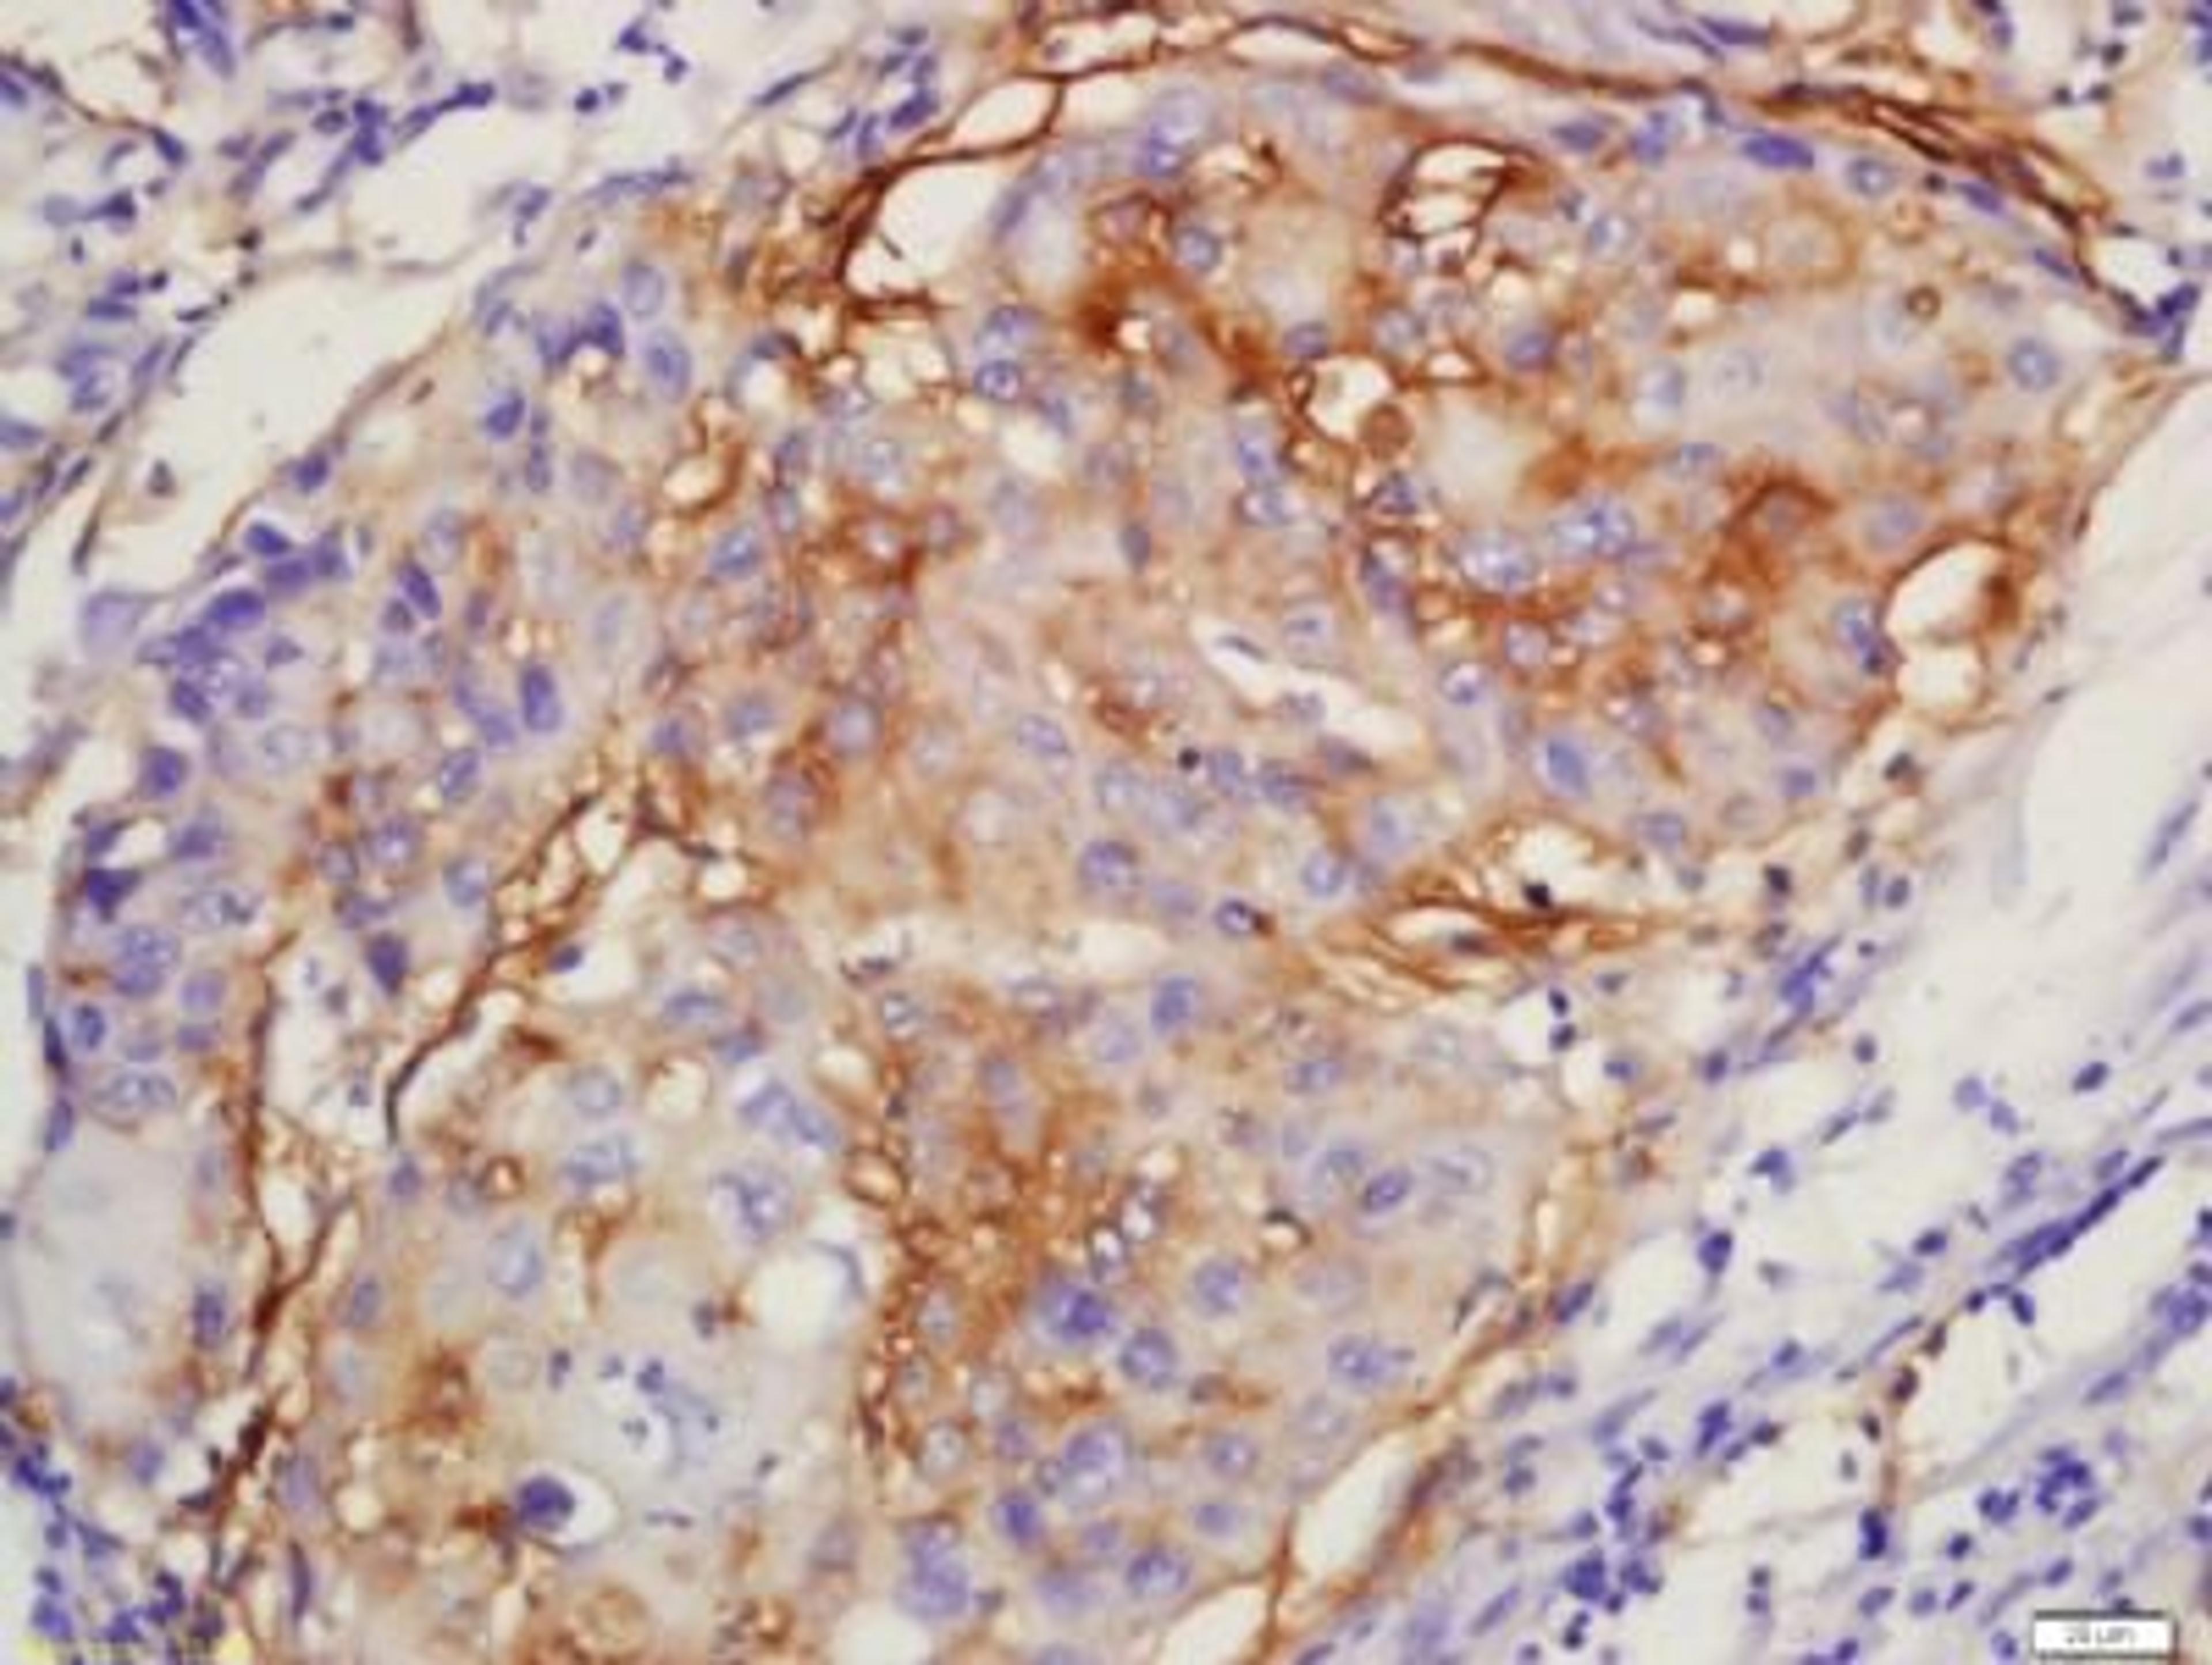
Immunohistochemical staining of human lung cancer tissue using ERK1 (phospho-Thr183-185) antibody.

Product & ReviewsAntibodies
Glucocorticoid Receptor (Phospho-Ser203) antibody
Product Details
- Cat. No.
- orb105971
- Type
- Primary Antibody
- Clonality
- Polyclonal
- Host
- Rabbit

The supplier does not provide quotations for this antibody through SelectScience. You can search for similar antibodies in our Antibody Directory.
Description
Rabbit polyclonal antibody to Glucocorticoid Receptor (Phospho-Ser203)
Biological Information
- Clonality: Polyclonal
- Host: Rabbit
- Reactivity: Human, Mouse
- Isotype: IgG
- Gene: 331
Handling
- Quantity: 50 µl, 100 µl, 20 µl (Trial size)
- Storage: Store at -20°C.Stable for 12 months from date of receipt.
- Buffer: Phosphate buffer saline, pH. 7.4, 150mM NaCl, 0.02% sodium azide and 50% glycerol.
Applications
- Western Blotting (WB)